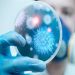
ماهو مرض السكابيس الجلدي 99 ماهو مرض السكابيس الجلدي

وكالات – غزة بوست
إقرأ : بنود المقترح الأمريكي المقدمه إلى مفاوضات الدوحه
كشف مصدر عن المقترح الأمريكي المقدم إلى مفاوضات الدوحة بشأن وقف إطلاق النار في غزة يتضمنمجموعة من البنود التي تعكس مطالب إسرائيلية رئيسية، وتؤكد على استدامة الاحتلال في بعض المناطقوتقييد حركات المقاومة الفلسطينية. من أبرز هذه البنود:
1. تقليص تواجد الجيش الإسرائيلي في محور فيلادلفيا**: بدلاً من الانسحاب الكامل، سيقتصرالتواجد العسكري الإسرائيلي في هذا المحور الحيوي.
2. إدارة معبر رفح**: سيتم إعادة السلطة الفلسطينية لإدارة معبر رفح، لكن تحت رقابة إسرائيلية لم يتمتحديد شكلها بعد.
3. المراقبة الإسرائيلية للنازحين العائدين**: يتم الإصرار على مراقبة النازحين العائدين إلى شمال قطاعغزة في منطقة نتساريم، دون تحديد كيفية هذه المراقبة.
4. إبعاد الأسرى الفلسطينيين المفرج عنهم**: سيتم إبعاد عدد كبير من الأسرى الفلسطينيين المفرجعنهم في صفقة التبادل إلى خارج فلسطين.
5. حق إسرائيل في رفض إطلاق سراح عدد من الأسرى**: تمنح إسرائيل الحق في رفض إطلاق سراحما لا يقل عن 100 أسير.
6. عدم الانسحاب من القطاع**: يتمسك المقترح بعدم الانسحاب الكامل من قطاع غزة.
7. الإغاثة مشروطة**: المساعدات الإنسانية والإغاثة ستكون مشروطة بموافقة حماس على هذه البنود.
8. مناقشة وقف إطلاق النار الدائم**: سيتم مناقشة وقف إطلاق النار الدائم في مرحلة ثانية، وإذا لمتوافق حماس على المطالب الإسرائيلية، يعود الجيش الإسرائيلي لمواصلة عملياته العسكرية.
9. إعادة إعمار غزة ورفع الحصار**: سيتم ترك هذه القضايا للمفاوضات المستقبلية التي ستلي تنفيذالمرحلة الأولى.
حركة حماس أعربت عن رفضها لهذه المقترحات، لكنها تنتظر الصيغة النهائية للمقترح الأمريكي قبل أنتعلن موقفها النهائي.